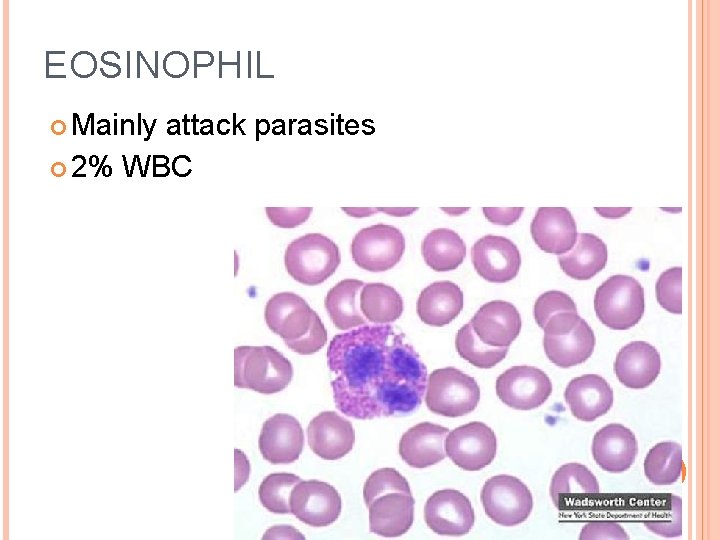
EOSINOPHIL Mainly attack parasites 2% WBC
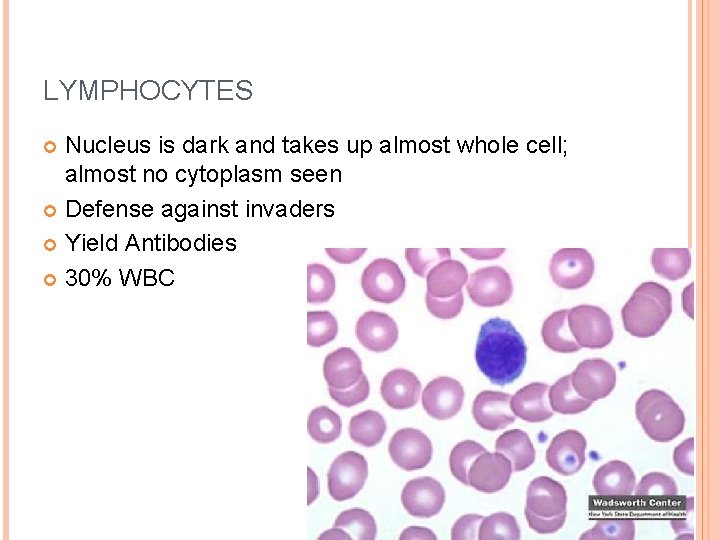
LYMPHOCYTES Nucleus is dark and takes up almost whole cell; almost no cytoplasm seen
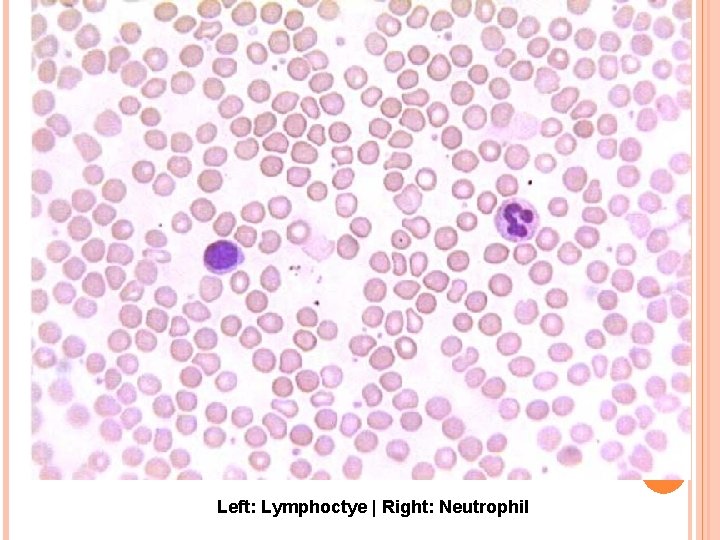
Left: Lymphoctye | Right: Neutrophil

BLOOD The Cardiovascular System Blood transports substances and

BLOOD The Cardiovascular System

Blood transports substances and maintains homeostasis in the body Hematophobia = fear of blood

BLOOD AND BLOOD CELLS Blood is a type of CONNECTIVE TISSUE It has two basic components: CELLS (rbc, wbc, platelets) = 45% Plasma (water, proteins, amino acids. . etc) = 55%

Hematocrit - volume of blood cells in a sample, should be 45%. The remaining fluid is plasma (55%). To determine the percentages, blood is placed in a centrifuge

Three Types of Blood Cells Red blood cells (erythrocytes) White blood cells (leukocytes) Platelets (thrombocytes)

Biconcave discs 5 million per cubic millimeter Lack nuclei HEMATOPOEISIS – formation of blood cells (bone marrow) Liver & Spleen - phagocytosis

EPO, OR ERYTHROPOIETIN (PRONOUNCED, AH-RITHRO-POY-TIN), IS A HORMONE PRODUCED BY THE LIVER AND KIDNEYS. In the first part of a two-night interview broadcast, disgraced cyclist Lance Armstrong admitted to Oprah Winfrey that he took banned substances, including EPO, during all seven of his Tour de France victories.

ERYTHROPOIETIN Erythropoietin (EPO) is a hormone produced by the kidney that promotes the formation of red blood cells by the bone marrow. The resultant rise in red cells increases the oxygen-carrying capacity of the blood. 90% erythropoietin is produced by the kidneys 10% erythropoietin is produced by the liver Normal levels of erythropoietin range from 4 up to 24 m. U/ml (milliunits per milliliter).



MAIN FUNCTIONS OF RED BLOOD CELLS Transports oxygen, picks up carbon dioxide HEMOGLOBIN - molecule that combines with O 2 IRON is critical to synthesize hemoglobin

OXYGEN LEVELS Oxyhemoglobin = plenty of oxygen; bright red Deoxyhemoglobin = low in O 2, “bluish red” The blood on the left is oxygenated, the right is deoxygenated blood (from a vein) OXYGENATED DEOXYGENATED

ELEMENTS CRITICAL TO RBC PRODUCTION Folic Acid Vitamin B 12 Iron Too few RBC = anemia

WHITE BLOOD CELLS (LEUKOCYTES) General function is to protect the body against disease There are FIVE different kinds of WBCs Granulocytes (granular cytoplasm) Neutrophils, Eosinophils, Basophils Agranulocytes (lacking granular cytoplasm)



NEUTROPHIL (NUCLEUS HAS SEVERAL LOBES) Active phagocytes 60% of WBC Present in the pus of wounds

BASOPHIL Produces Heparin and Histamines Important in Inflammatory Reaction 1% WBC
EOSINOPHIL Mainly attack parasites 2% WBC

MONOCYTE Larger cell, horseshoe-shaped nucleus Become macrophages
LYMPHOCYTES Nucleus is dark and takes up almost whole cell; almost no cytoplasm seen Defense against invaders Yield Antibodies 30% WBC
Left: Lymphoctye | Right: Neutrophil

ANIMATION: IMMUNE SYSTEM RESPONSE


PLATELETS (THROMBOCYTES) Blood clots and vessel repair

ERYTHROPOIESIS – DESCRIBES THE PRODUCTION OF RED BLOOD CELLS The red bone marrow of essentially all bones produces RBCs from birth to about five years of age. Between the ages of 5 to 20, the long bones slowly lose their ability to produce RBCs. Above age 20, most RBCs are produced primarily in the marrow of the vertebrae, the sternum, the ribs, and the pelvis.

ERYTHROPOIESIS – DESCRIBES THE PRODUCTION OF RED BLOOD CELLS

LIFE CYCLE OF THE RED BLOOD CELL -120 DAYS 1) Kidneys respond to a lower than normal oxygen concentration in the blood by releasing the hormone erythropoietin. 2) Erythropoietin travels to the red bone marrow and stimulates an increase in the production of red blood cells (RBCs). 3) The red bone marrow manufactures RBCs from stem cells that live inside the marrow. 4) RBCs squeeze through blood vessel membranes to enter the circulation. 5) The heart and lungs work to supply continuous movement and oxygenation of RBCs. 6) Damaged or old RBCs are destroyed primarily by the spleen

PLASMA PROTEINS Albumins – blood pressure Globulins (alpha, beta, gamma) – transport lipids and antibodies for immunity Fibrinogen – important for blood clotting MAJOR EVENT IN BLOOD CLOTTING = Fibrinogen converted to FIBRIN

PLASMA The liquid portion of blood is 92% water Also contains nutrients, gases, vitamins (etc) and plasma proteins

This machine removes the plasma from the blood and returns the RBC’s to the donor.

HEMOSTASIS The process of stopping bleeding Involves the coagulation and clotting of the blood to seal the site of damage

THREE EVENTS IN HEMOSTASIS 1. Blood Vessel Spasm Seratonin = vasoconstrictor 2. Platelet plug formation 3. Blood coagulation - conversion of fibrinogen to fibrin *Thrombin is an enzyme that causes the conversion

HEMOSTASIS

COAGULATION - THE THICKENING OF BLOOD TO FORM A CLOT (HEMATOMA)

THROMBUS – blood clot (abnormal) EMBOLUS – when the clot moves to another place.
- Slides: 36